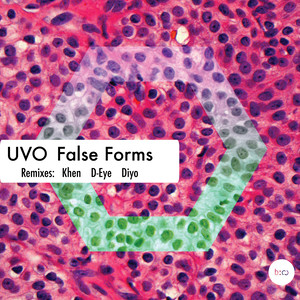

Uvo
热门歌曲
-
Uvo 6.8 MB 07:25
-
Uvo、Violka Marcinkiewicz 2.32 MB 02:31
-
Uvo 2.7 MB 02:56
-
Uvo 2.53 MB 02:45
-
Driguezro (mx)、Uvo 6.25 MB 06:49
-
Driguezro (mx)、Uvo 6.73 MB 07:21
-
Uvo、Navid Mehr 6.54 MB 07:08
-
TKR DA DJ、Olgar、Uvo、Jay Magazi 4.19 MB 04:34
-
Ewan Rill、Anton Ttx、Hugo Ibarra、Uvo 6.85 MB 07:29
-
Don El Malo、SRIFI 44、Hamzafnx、The Besko、Uvo 5.32 MB 05:48
-
Uvo 6.67 MB 07:17
-
Uvo 6.73 MB 07:21
-
Uvo 6.73 MB 07:21
-
Uvo 6.8 MB 07:25
-
Uvo 6.8 MB 07:25
-
-
Platunoff、Hugo Ibarra、Uvo 8.42 MB 09:12
-
Platunoff、Hugo Ibarra、Uvo 8.42 MB 09:12
-
Kastis Torrau、Uvo 6.46 MB 07:03
-
Lautaro Varela、Uvo、Nikko.Z 6.23 MB 06:47
-
Chris Gavin、Uvo 7.27 MB 07:56
-
Uvo、Lautaro Varela 6.23 MB 06:47
-
Uvo、Lautaro Varela 5.7 MB 06:13
-
Uvo、Lautaro Varela 6.23 MB 06:47
-
Dousk、Lautaro Varela、Uvo 7.78 MB 08:30
-
Uvo 6.72 MB 07:20
-
Uvo 6.92 MB 07:33
-
Uvo 6.54 MB 07:08